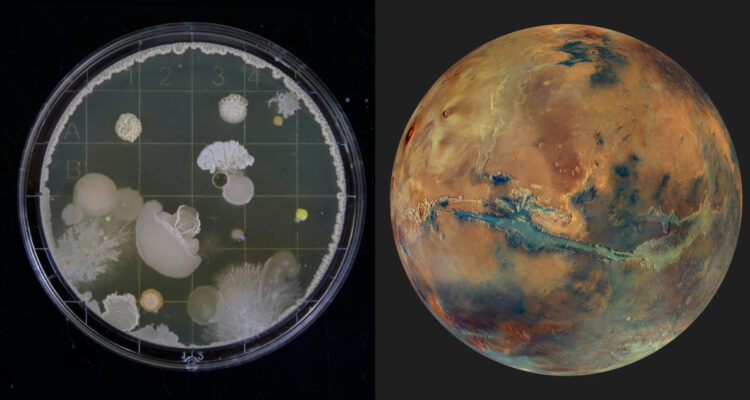
¿Vida marciana? Los extraños seres que viven en el fondo de la Tierra y que podrían estar en Marte

Recientemente, un nuevo estudio sugirió la posibilidad de que en el interior de Marte exista una gran reserva de agua, lo que realzó la teoría sobre la presencia de vida en el planeta rojo. Si existiera, esta sería subterránea.
De hecho, en el interior de la Tierra viven extraños y diversos organismos. Los biólogos que estudian nuestro planeta han reunido evidencia durante décadas. Para este tipo de estudios se perforó el fondo marino a grandes profundidades y se ha encontrado vida microbiana.
De acuerdo con un artículo de BBC News, la mayoría de estos organismos que logran habitar allí son unicelulares, las bacterias o arqueas, que son las formas de vida más antiguas de la Tierra. Recordemos que, existen hace unos 3.000 millones de años, antes que animales y plantas.
Los científicos dicen que en el interior de la Tierra hay una especie de biósfera, que es como se le llama a la capa donde existe la vida en la superficie. “En realidad, hay muchos tipos diferentes de organismos que viven en el subsuelo“, dijo al medio, Cara Magnabosco, geobióloga de la ETH de Zúrich, en Suiza.
En los últimos años, se han identificado diferentes tipos de bacterias e incluso algunas no conocidas. Estos organismos se consideran “raros” porque viven en la completa oscuridad y no pueden obtener energía del Sol, “están completamente desconectados de la superficie”, añadió Magnabosco.
En resumen, estos seres vivos se mantienen gracias a la quimiosíntesis. Según la National Oceanic and Atmospheric Administration, “es el proceso mediante el cual las bacterias u otros seres vivos elaboran alimentos utilizando sustancias químicas como fuente de energía, generalmente en ausencia de luz solar”. Estas sustancias químicas la consiguen de las rocas o el agua en su entorno.
¿Vida en Marte?
Ahora, con la presencia de agua en las profundidades de Marte, se puede barajar la posibilidad de la existencia de bacterias en el subsuelo. El estudio que encontró agua al interior del planeta obtuvo sus datos a partir de mediciones del módulo Insight, que estuvo activo en Marte, captando datos de su superficie y el movimiento del suelo.
El Insight recogió las vibraciones de terremotos marcianos y estos estarían revelando señales sísmicas de agua líquida. “En realidad, son las mismas técnicas que utilizamos para buscar agua en la Tierra o petróleo y gas“, comentó entonces el profesor Michael Manga, de la Universidad de California, en Berkeley, que participó en la investigación.
Si bien, ya se ha demostrado la presencia de agua en Marte, congelada en los polos, esta sería la primera vez que los científicos descubren agua líquida.
“Nuestros hallazgos significan que hay entornos que posiblemente podrían ser habitables“, señlaó Vashan Wright, de la Universidad de California (UC) Berkeley y profesor adjunto en la Institución Scripps de Oceanografía de la UC San Diego, quien dirigió la investigación.
“Sin agua líquida no hay vida. Por lo tanto, si hay entornos habitables en Marte, es posible que ahora se encuentren en las profundidades del subsuelo”, concluyó Manga.
Por el momento, todo indica que los humanos están más cerca de descubrir organismos vivos fuera de la Tierra, aunque perforar Marte para comprobar la presencia de vida bacteriana podría tomar décadas.







 Enviando corrección, espere un momento...
Enviando corrección, espere un momento...